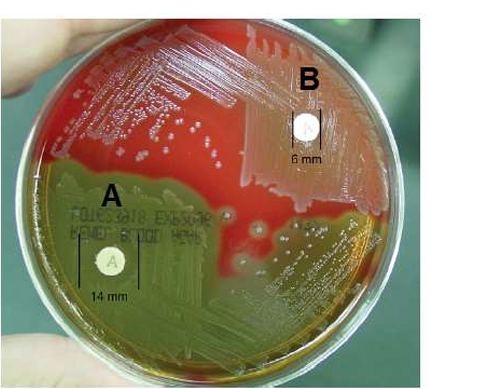

النبات

مواضيع عامة في علم النبات

الجذور - السيقان - الأوراق

النباتات الوعائية واللاوعائية

البذور (مغطاة البذور - عاريات البذور)

الطحالب

النباتات الطبية


الحيوان

مواضيع عامة في علم الحيوان

علم التشريح

التنوع الإحيائي

البايلوجيا الخلوية


الأحياء المجهرية

البكتيريا

الفطريات

الطفيليات

الفايروسات


علم الأمراض

الاورام

الامراض الوراثية

الامراض المناعية

الامراض المدارية

اضطرابات الدورة الدموية

مواضيع عامة في علم الامراض

الحشرات


التقانة الإحيائية

مواضيع عامة في التقانة الإحيائية


التقنية الحيوية المكروبية

التقنية الحيوية والميكروبات

الفعاليات الحيوية

وراثة الاحياء المجهرية

تصنيف الاحياء المجهرية

الاحياء المجهرية في الطبيعة

أيض الاجهاد

التقنية الحيوية والبيئة

التقنية الحيوية والطب

التقنية الحيوية والزراعة

التقنية الحيوية والصناعة

التقنية الحيوية والطاقة

البحار والطحالب الصغيرة

عزل البروتين

هندسة الجينات


التقنية الحياتية النانوية

مفاهيم التقنية الحيوية النانوية

التراكيب النانوية والمجاهر المستخدمة في رؤيتها

تصنيع وتخليق المواد النانوية

تطبيقات التقنية النانوية والحيوية النانوية

الرقائق والمتحسسات الحيوية

المصفوفات المجهرية وحاسوب الدنا

اللقاحات

البيئة والتلوث


علم الأجنة

اعضاء التكاثر وتشكل الاعراس

الاخصاب

التشطر

العصيبة وتشكل الجسيدات

تشكل اللواحق الجنينية

تكون المعيدة وظهور الطبقات الجنينية

مقدمة لعلم الاجنة


الأحياء الجزيئي

مواضيع عامة في الاحياء الجزيئي


علم وظائف الأعضاء


الغدد

مواضيع عامة في الغدد

الغدد الصم و هرموناتها

الجسم تحت السريري

الغدة النخامية

الغدة الكظرية

الغدة التناسلية

الغدة الدرقية والجار الدرقية

الغدة البنكرياسية

الغدة الصنوبرية

مواضيع عامة في علم وظائف الاعضاء

الخلية الحيوانية

الجهاز العصبي

أعضاء الحس

الجهاز العضلي

السوائل الجسمية

الجهاز الدوري والليمف

الجهاز التنفسي

الجهاز الهضمي

الجهاز البولي


المضادات الميكروبية

مواضيع عامة في المضادات الميكروبية

مضادات البكتيريا

مضادات الفطريات

مضادات الطفيليات

مضادات الفايروسات

علم الخلية

الوراثة

الأحياء العامة

المناعة

التحليلات المرضية

الكيمياء الحيوية

مواضيع متنوعة أخرى

الانزيمات
اختبار حساسية الباسيتراسين Bacitracin Susceptibility
المؤلف:
م.م. عباس حميد شكور الونداوي , أ.د. لمى عبد الهادي زوين
المصدر:
الاختبارات الكيموحيوية التشخيصية للبكتيريا
الجزء والصفحة:
ص18
2024-12-26
1169
الغرض من الاختبار Purpose
يستعمل هذا الاختبار في التشخيص التخميني والتمييز بين بكتيريا العقدية القيحية مجموعة A الحساسة( - susceptible group AStreptococcus pyogenes) المحللة للدم نوع بيتا والانواع الاخرى من البكتيريا العقدية. كما أنها تستعمل للتمييز بين أنواع المكورات العنقودية (المقاومة) من المكورات الدقيقة Micrococci ( الحساسة ) للباستراسين.
مبدأ الاختبار Principle
يثبط المضاد الحيوي باسيتراسين Bacitracin بناء جدار الخلية البكتيرية. اذا يستعمل قرص (TaxoA) الحاوي (0,04) وحدة من المضاد باسيتراسين، اذ يوضع القرص على سطح الطبق الزرعي ويتم انتشار المضاد في الوسط الزرعي و بعد مدة الحضن تفحص الاطباق المزروعة والتحري عن مناطق التثبيط inhibition zones حول قرص مضاد الباسيتراسين.
النتائج المتوقعة Expected Results
* النتيجة موجبة (حساسة ( اذا كانت منطقة التثبيط اكثر من 10ملم حول القرص ).
* النتيجة سالبة (مقاومة ) عدم وجود منطقة تثبيط .
ملاحظات
1- تعتمد النتيجة على سلامة القرص.
2 - يجب أن تكون الاقراص ضمن صلاحية الاستعمال مع متابعة تواريخ التخزين باستمرار .
الاكثر قراءة في البكتيريا
اخر الاخبار
اخبار العتبة العباسية المقدسة
الآخبار الصحية

قسم الشؤون الفكرية يصدر كتاباً يوثق تاريخ السدانة في العتبة العباسية المقدسة
"المهمة".. إصدار قصصي يوثّق القصص الفائزة في مسابقة فتوى الدفاع المقدسة للقصة القصيرة
(نوافذ).. إصدار أدبي يوثق القصص الفائزة في مسابقة الإمام العسكري (عليه السلام)